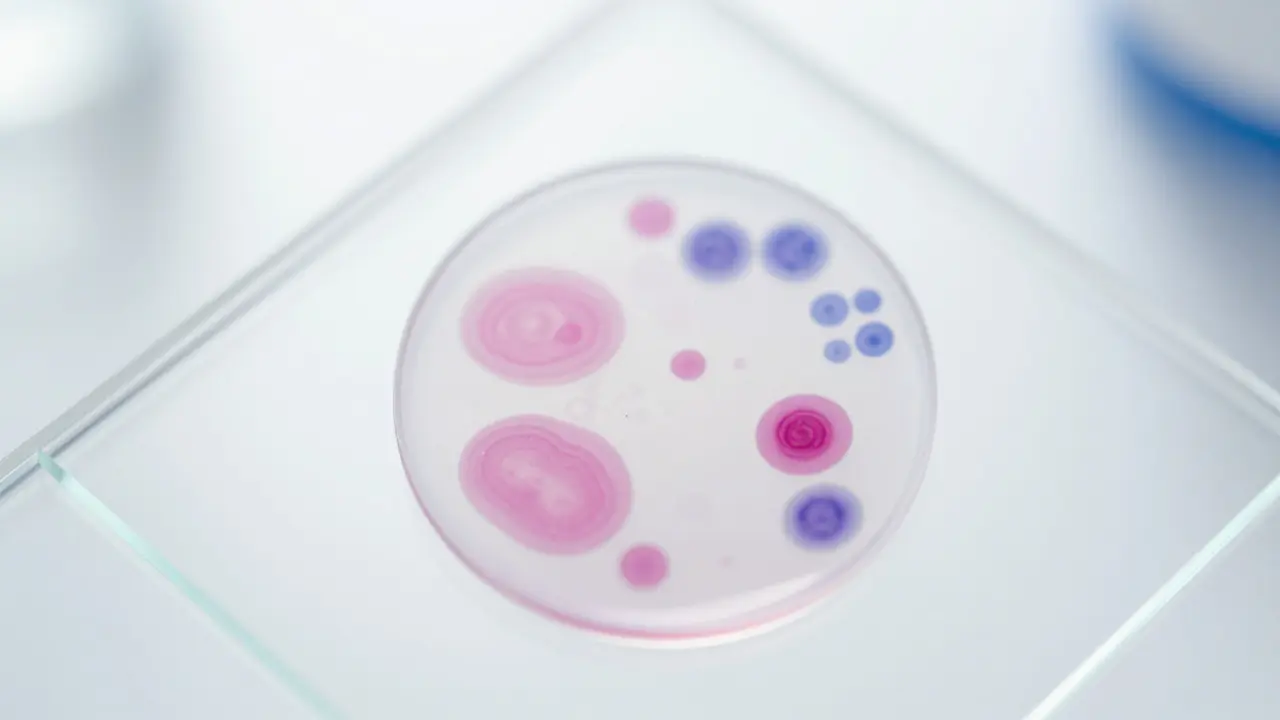
Umělecký detail citologického vzorku na sklíčku v moderní laboratorní atmosféře.

Kalkulátor intervalů preventivních prohlídek
Kdy jít znovu na kontrolu?
Výsledek:
Tip: Pokud jste v rizikové skupině nebo zaznamenáte jakékoli změny, kontaktujte lékaře okamžitě bez ohledu na tento datum.
Zadejte datum a typ prohlídky pro výpočet doporučeného termínu.
Mnoho žen vnímá preventivní prohlídky jako nutné zlo nebo stresující rituál, který se snaží co nejdéle odsunout. Možná jste na své kartičce nebo v aplikaci uviděla připomínku, že je čas na tzv. pětiletou kontrolu, a teď přemýšlíte, v čem se liší od té klasické roční. Je to jen formality, nebo se skutečně něco jiného děje? Pravdou je, že zatímco roční kontrola je o udržování hygieny a sledování cyklu, 5letá prohlídka je hlubší bezpečnostní sítí, která má za cíl zachytit vážné změny v těle dříve, než se stanou problémem.
Klíčové rozdíly mezi roční a pětiletou kontrolou
Abychom pochopili, co ta pětiletá obnáší, musíme se podívat na to, co děláme každý rok. Standardní preventivní prohlídka zahrnuje fyzikální vyšetření, hmatovou kontrolu prsů a základní gynekologickýv přezkum. Pětiletá kontrola však přidává specifické testy, které by při každé návštěvě byly zbytečné nebo příliš invazivní, ale jednou za pět let jsou naprosto klíčové pro vaše zdraví.
Hlavním rozdílem je zaměření na screeningy. Zatímco ročně sledujeme aktuální stav, pětiletý cyklus je nastavěn tak, aby odpovídal biologickému tempu vývoje některých onemocnění, zejména těch onkologických. Pokud hledáte gynekologie Praha, pravděpodobně zjistíte, že většina klinik tyto dva typy prohlídek striktně rozlišuje v rámci preventivního kalendáře.
Co všechno pětiletá prohlídka obsahuje?
Základem je samozřejmě standardní vyšetření, ale k tomu přicházejí následující kroky:
- Citologický přezkum: I když se citologie často dělá častěji (např. každé 3 roky), u pětileté kontroly je zásadním bodem. Jde o odebrání vzorku z cervixu (šíjky dělohy), aby se vylučily atypické změny buněk.
- Krevní obraz a biochemie: Lékař může doporučit základní krevní testy, aby ověřil funkci ledvín, jater a celkovou imunitu.
- Rozšířená palpační kontrola: Důkladnější prohmatávání prsů a podpažních uzlin, někdy v kombinaci s doporučením na screeningové vyšetření.
- Diskuse o hormonální substituci: Pokud jste ve věku blízkém menopauze, pětiletá kontrola je ideálním časem na revizi vašich hormonálních hladin a úpravu medikace.
Důležitým prvkem je také revize vašeho anamnestického listu. Lékař se vás zeptá na změny v rodinné historii - zda se v rodině neobjevily nové diagnózy rakoviny prsu nebo vaječníků, což může změnit frekvenci vašich budoucích návštěv.
| Kritérium | Roční kontrola | 5letá prohlídka |
|---|---|---|
| Časová frekvence | Každý rok | Jednou za 5 let |
| Hlavní cíl | Aktuální stav a hygiena | Dlouhodobý screening |
| Základní vyšetření | Ano | Ano |
| Hloubková revize historie | Základní | Detailní |
| Specifické testy | Minimum | Rozšířený screening |
Proč je citologie tak zásadní?
Když mluvíme o pětileté kontrole, mluvíme v podstatě o prevenci rakoviny. Citologie je v podstatě „střežný pes“ vašeho zdraví. Pomáhá odhalit dysplazie, což jsou předrakovinné změny na šijce dělohy. Pokud se tyto změny zachytí včas, lze je odstranit jednoduchým zákrokem, aniž byste musely procházet agresivní léčbou.
Mnoho žen se ptá, proč to dělat, když nemají žádné potíže. Právě v tom je ten háček: rakovina šijky dělohy v raných stádiích prakticky nebolí a neprojevuje se žádným krvácením ani výpludkem. Jediný způsob, jak ji najít, je právě pravidelný cytologický přezkum. V kombinaci s testem na HPV (lidský papilomavirus) se tak z preventivní prohlídky stává skutečný záchranář životů.
Na co se připravit a jak probíhá vyšetření?
Nebojte se, pětiletá prohlídka není žádný maraton. Celý proces obvykle trvá kolem 30 až 45 minut. Nejdříve proběhne pohovor, kde proberete vaše potíže, cyklus a případné léky. Poté následuje samotné vyšetření na gynekologickém křesle. Lékař provede vnitřní vyšetření, odebere citologii a zkontroluje vaječníky.
Pro pohodlí doporučujeme jít na prohlídku v době, kdy nejste v menstruačním krvácení (ideálně 5-7 dní po skončení), protože krev může zkomplikovat interpretaci citologického vzorku. Pokud máte pocit, že jste v posledním roce zaznamenaly nějaké změny v sekreci nebo bolestivost při styku, určitě to lékaři řekněte hned na začátku.
Časté mýty o preventivních prohlídkách
„Když mě nic netrápí, nemusím tam jít.“ To je nejnebezpečnější mýtus všech. Prevence není o hledání nemocí, které už máte, ale o tom, abyste je předešly. Preventivní gynekologie funguje jako servis u auta - neměníte olej až v momentě, kdy motor přestane fungovat, ale děláte to proto, aby neprzestal.
Další mýtus je strach z bolesti. Moderní přístupy v gynekologii, zejména v soukromých centrech, kladou velký důraz na citlivost. Pokud máte negativní zkušenosti z minulosti, neváhejte říct lékaři, že jste nervózní. Použití menšího zrcadla nebo více času na relaxaci může celý zážitek změnit z traumatického na rutinní.

Jak se připravit, aby vyšetření proběhlo hladce?
Abyste z návštěvy měla maximum, doporučuji si připravit jednoduchý seznam. Zapište si datum poslední menstruace, seznam užívaných vitamínů a doplňků stravy a případné otázky, které vám vrtají v hlavě. Tímself ušetříte čas i sobě i lékaři.
- Sledujte svůj cyklus: Zvolte termín mimo menstruaci.
- Nepřehánějte to s hygienou: Před prohlídkou nepoužívejte vaginální sprchy ani intimní gely, které by mohly změnit pH sliznice a zkreslit výsledky.
- Klid a relaxace: Zkuste se před vyšetřením zhluboka nadechnout. Napjaté svaly pánve mohou vyšetření znepříjemnit.
Je 5letá prohlídka povinná?
Slovo „povinná“ v medicíně neexistuje, ale je to vysoce doporučený standard péče. Pokud ji zanedbáte, riskujete, že přehlédnete změny, které by byly včas cureabilní. Většina zdravotních pojišťoven tyto preventivní prohlídky plně hradí.
Musím na pětiletou kontrolu i když jsem v menopauze?
Ano, rozhodně. I po menopauze je citologický přezkum a kontrola vaječníků nezbytná. Riziko některých typů nádorů se s věkem paradoxně nezvyšuje lineárně, ale mění se jejich charakter, takže screeningy zůstávají klíčové.
Co když citologie vyjde abnormální?
Klidně, abnormální nález neznamená rakovinu. Často jde o zánět nebo benigní změny. Dalším krokem je obvykle kolposkopie, kde lékař prohlédne šijku pod zvětšením a případně odebere malý kousek tkáně k histologii pro přesnou diagnózu.
Kdy přesně mám jít na tuto kontrolu?
Ideálně jednou za pět let, pokud váš lékař nedoporučil jiný interval na základě vašich předchozích výsledků. Pokud jste však v rizikové skupině (např. genetická zátěž), může být interval kratší.
Zahrnuje pětiletá prohlídka i ultrazvuk?
Většina moderních gynekologických praktik standardně př přidá vaginální ultrazvuk k kontrolě vaječníků a endometria, i když to není v každém základním preventivním programu povinné. Doporučujeme se na to zeptat svého lékaře.
Další kroky pro vaše zdraví
Po pětileté kontrole nezapomeňte na svou vlastní roli. Žádný lékař nenahradí pravidelné samokontroly prsů, které byste měla dělat jednou měsíce po menstruaci. Pokud si všimnete jakékoliv změny v kształtu prsu, kůži nebo cítíte neznámý uzlík, nečekejte na žádný pětiletý nebo roční interval. Jděte na kontrolu okamžitě.
Pokud jste v Praze a hledáte si nového lékaře, zaměřte se na praxe, které nabízejí komplexní screeningy a mají moderní vybavení pro ultrazvukovou diagnostiku. Správně zvolený gynekolog z vás udělá partnera v péči o zdraví, ne jen pacientku, která přichází na vyšetření z povinnosti.


Menu